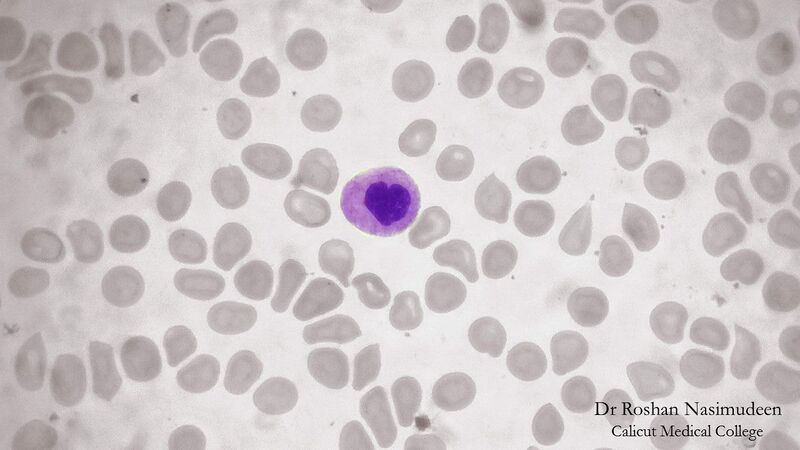
ملف:Neutrophil 1.jpg

ملف:Neutrophil 1.jpg
حجم هذه المعاينة: 800 × 450 بكسل. البعد الآخر: 1٬280 × 720 بكسل.
الملف الأصلي (1٬280 × 720 بكسل حجم الملف: 116 كيلوبايت، نوع MIME: image/jpeg)
وصف قصير
| Description |
English: Cytolology of neutrophil. |
| Date | 2017-03-24 |
| Source | Department of Pathology, Government Medical College, Kozhikode |
| Author | Dr. Roshan Nasimudeen |
| ⧼wm-license-information-permission⧽ (⧼wm-license-information-permission-reusing-text⧽) |
قالب:PermissionTicket |
ترخيص
|
|
هذا الملفُّ مُرخَّص بموجب رخصة المشاع الإبداعي نسبة المُصنَّف إِلى مؤلفه - المشاركة بالمثل 3.0 العامة. |
تاريخ الملف
اضغط على زمن/تاريخ لرؤية الملف كما بدا في هذا الزمن.
| زمن/تاريخ | صورة مصغرة | الأبعاد | مستخدم | تعليق | |
|---|---|---|---|---|---|
| حالي | ★ مراجعة معتمدة 03:57، 28 نوفمبر 2023 |  | 1٬280 × 720 (116 كيلوبايت) | Pastakhov (نقاش | مساهمات) | Upload https://upload.wikimedia.org/wikipedia/commons/e/e9/Neutrophil_1.jpg |
لا يمكنك استبدال هذا الملف.
وصلات
لا يوجد صفحات تصل لهذه الصورة.